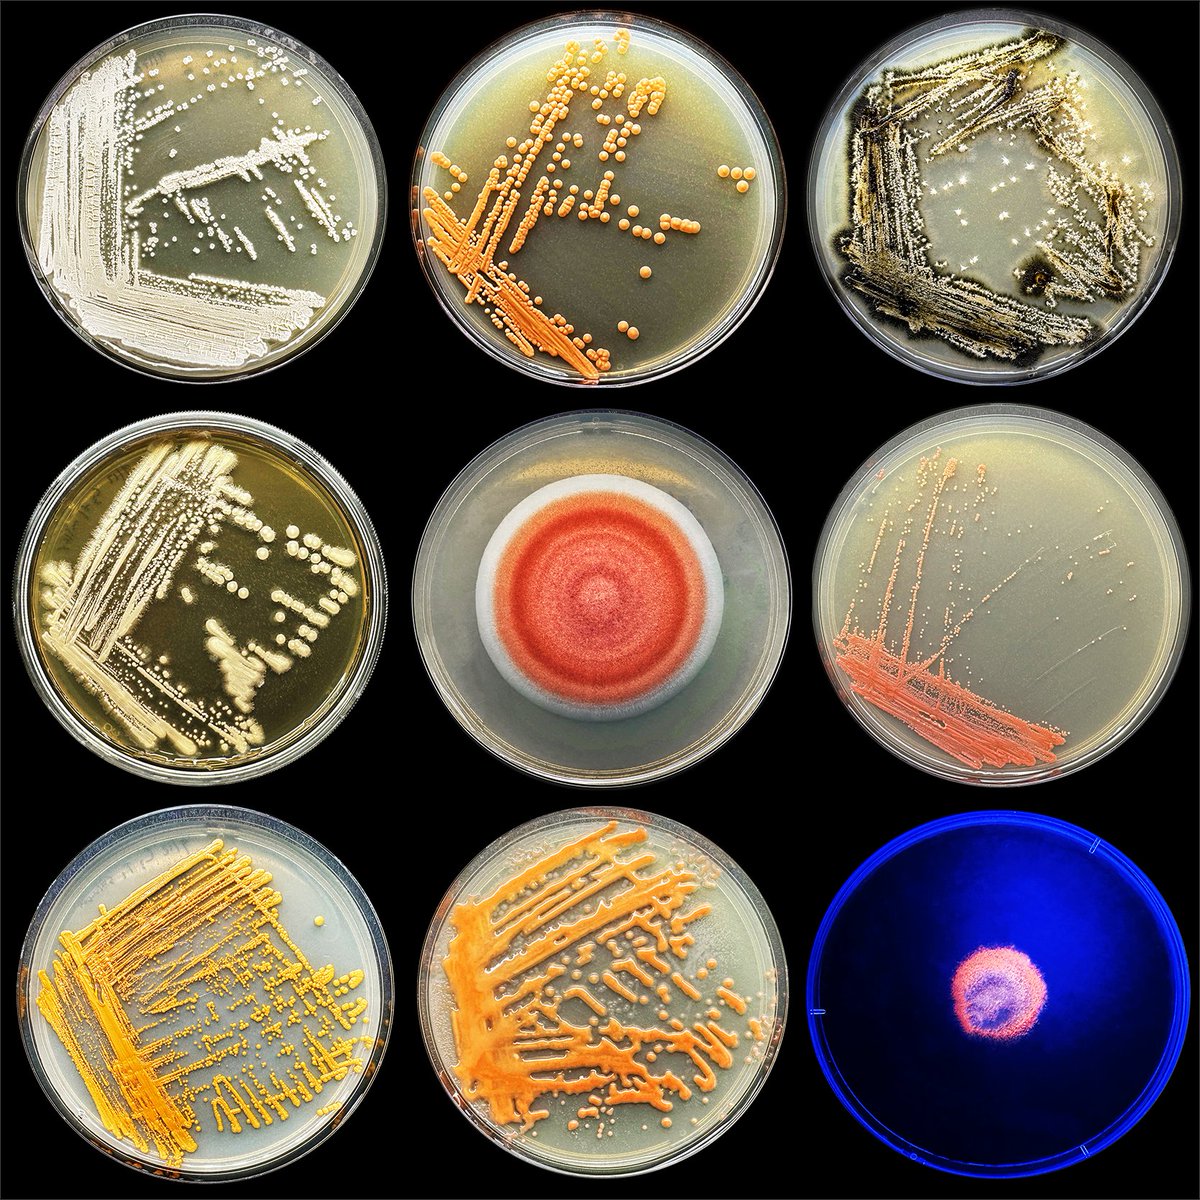
Josh McGinnis tweet media

Here're some basidiomycetous yeasts isolated in a recent bioprospecting gig. Most are the first reports of the species in Virginia on iNaturalist! #fungi #yeast #mycology #mushrooms

English
Josh McGinnis
13 posts

@everymanbio
Indie scientist, software engineer and fungi researcher.